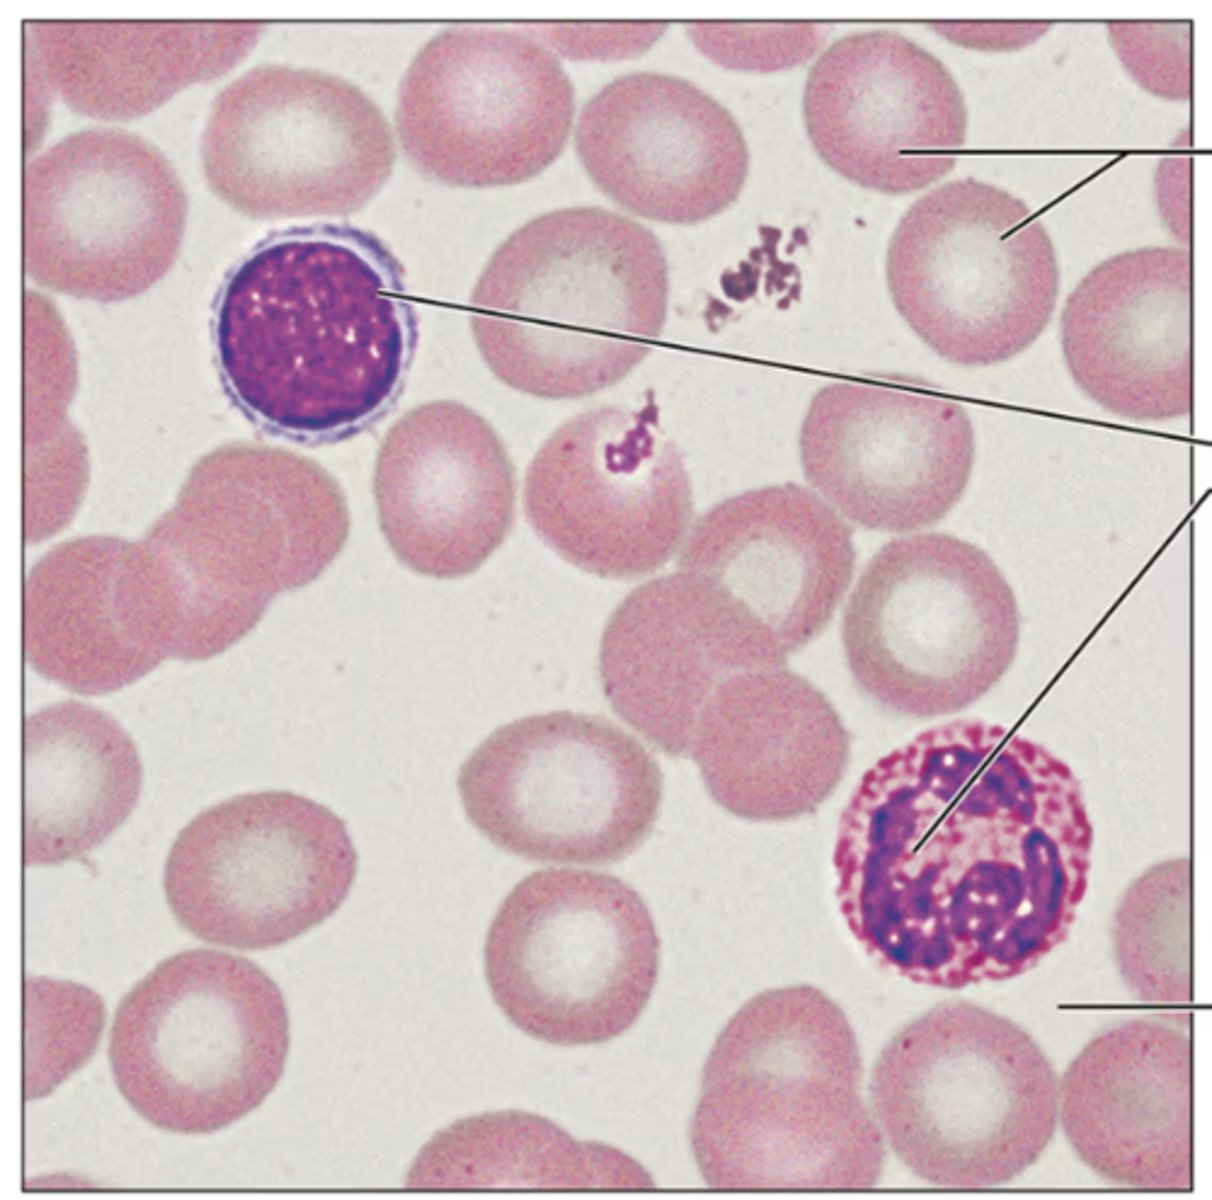
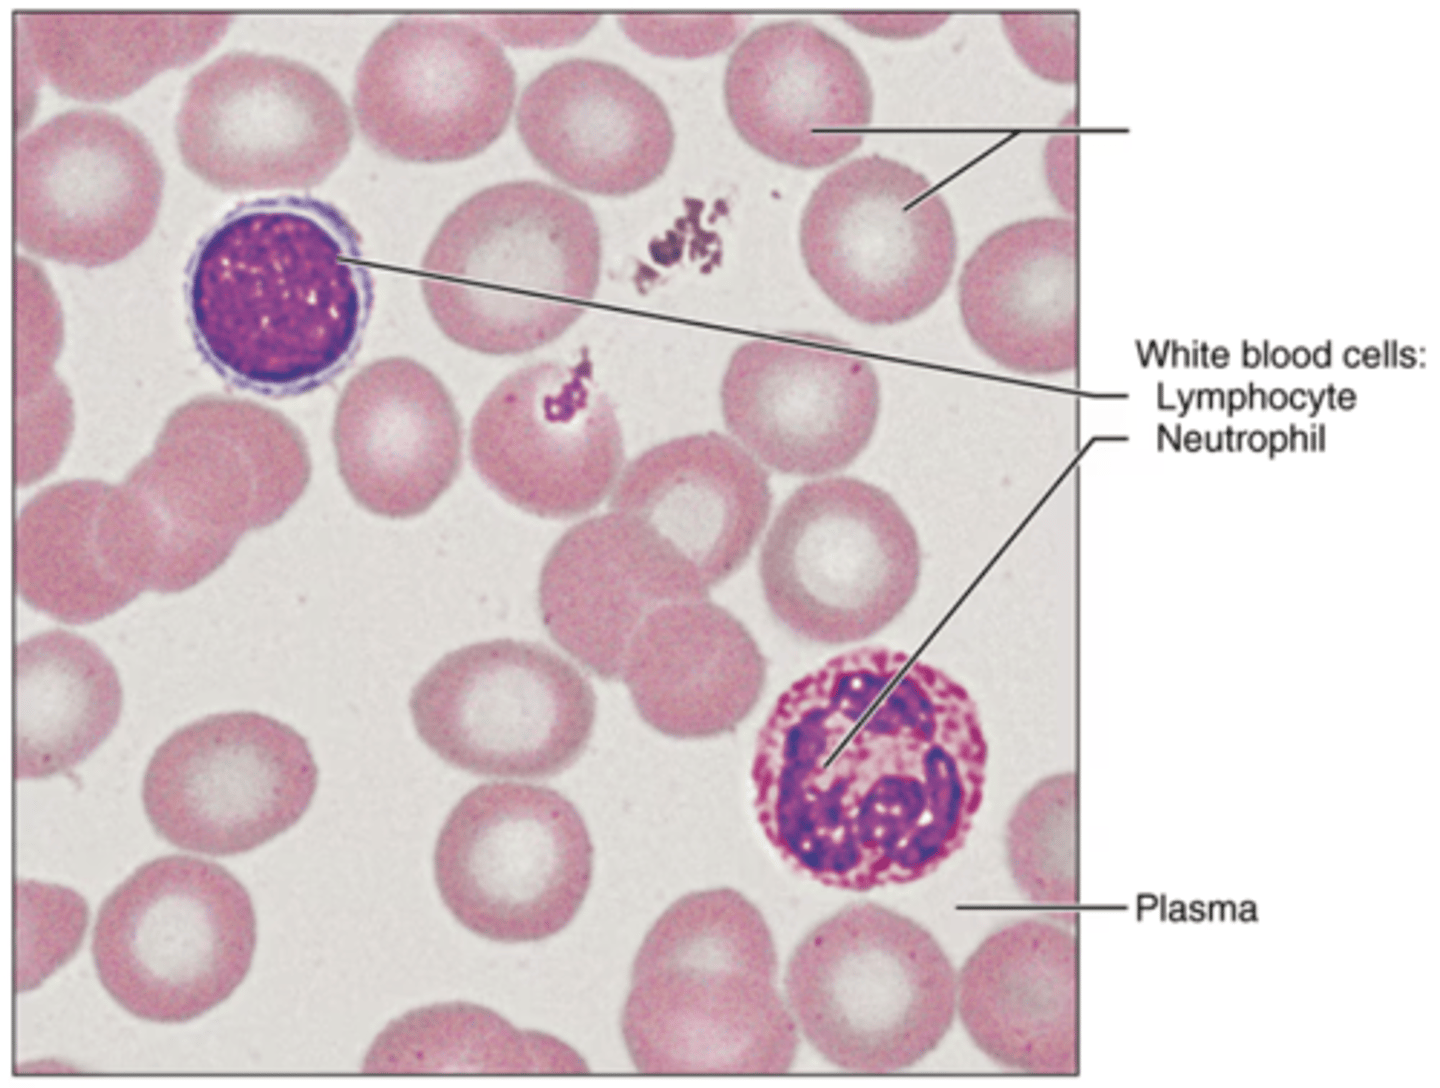
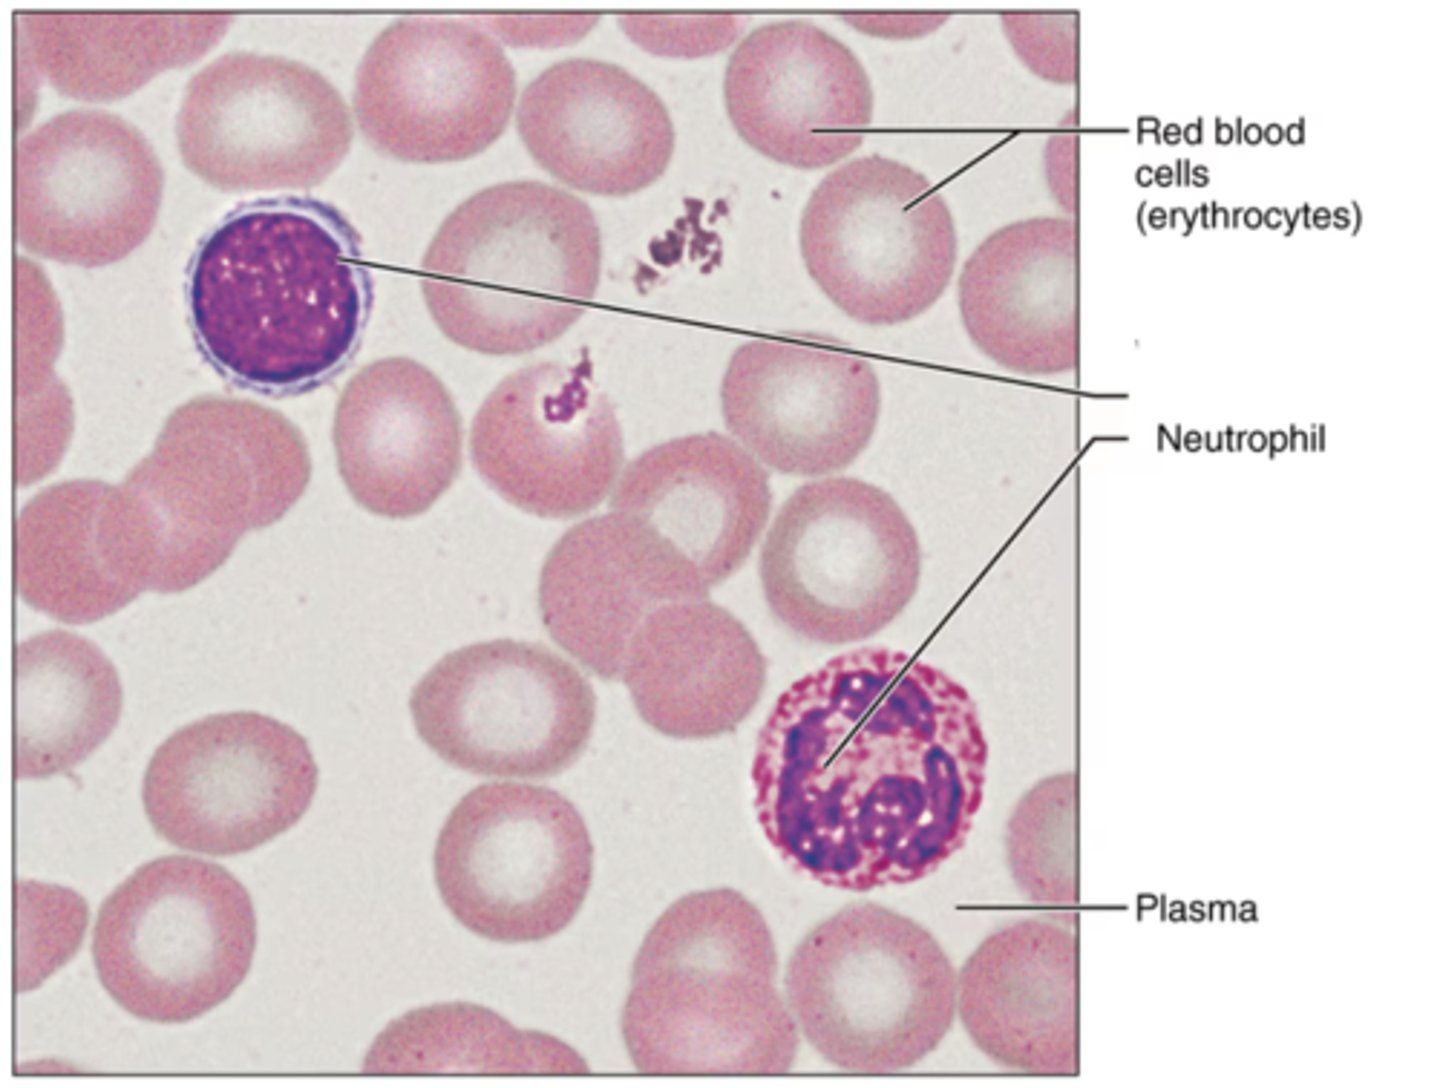
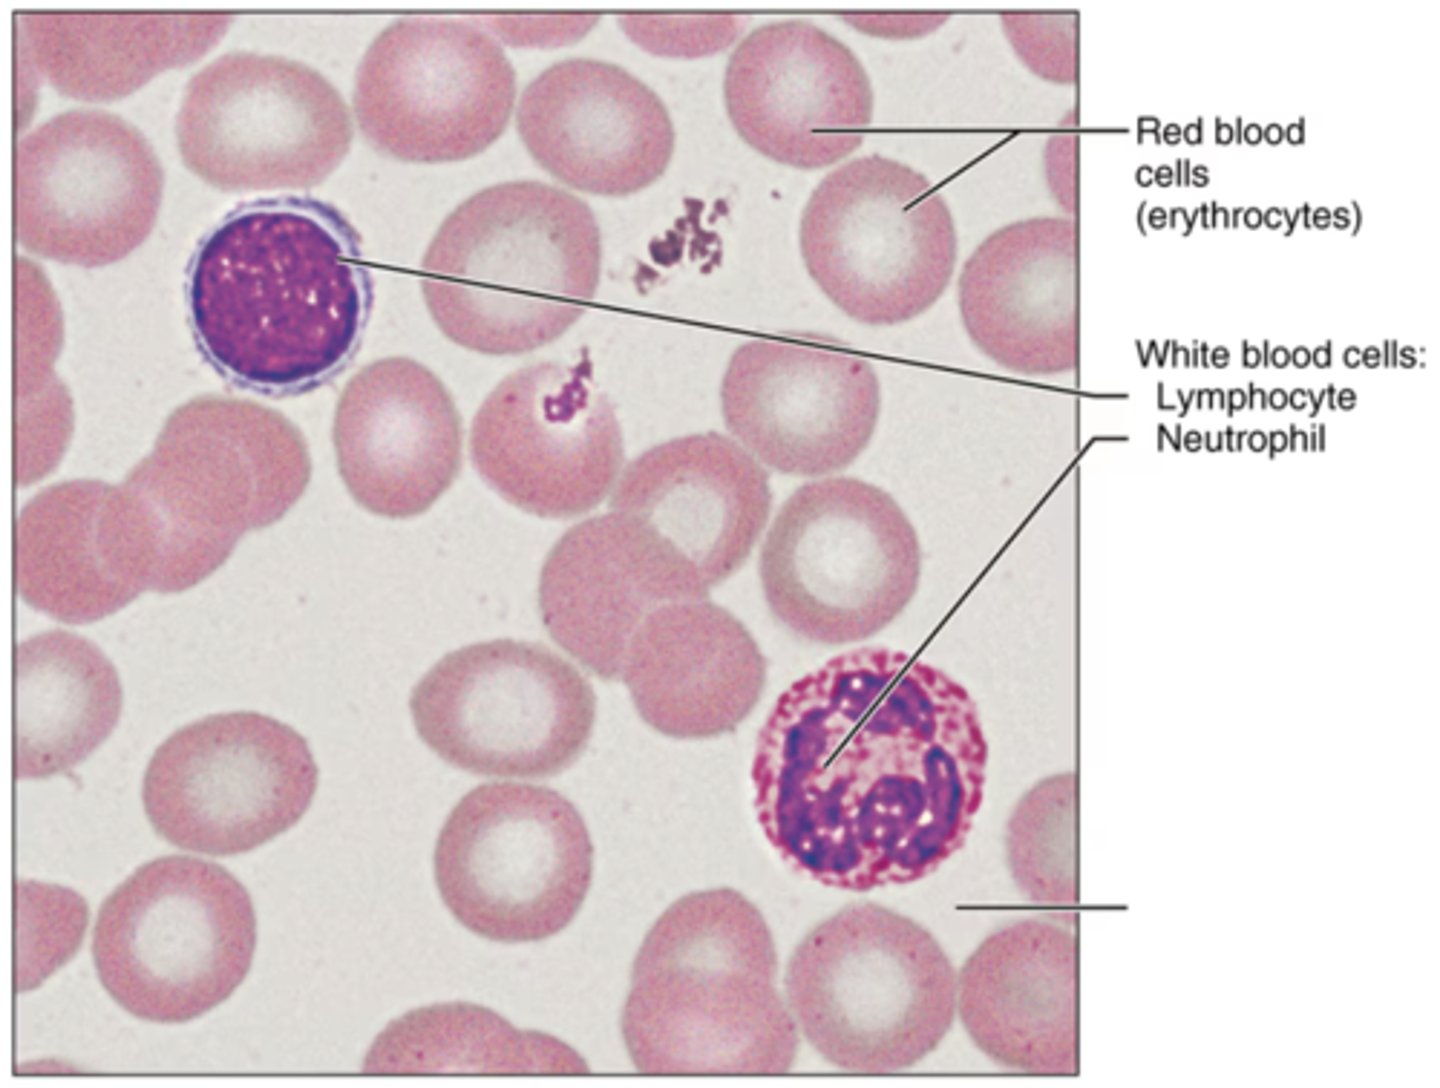

BIOL 231 - General Human Anatomy - Lab 2 - Histology or Microscopic Anatomy (slides only)
1/81
There's no tags or description
Looks like no tags are added yet.
Name | Mastery | Learn | Test | Matching | Spaced |
|---|
No study sessions yet.
82 Terms
Simple Squamous ET
Identify the tissue.

lumen (air sacs of the lung tissue)
Label the blank structure.

nuclei of squamous ET
Label the blank structure.

Simple Cubiodal ET
Identify the tissue.

nucleus
Label the blank structure.

basement membrane
Label the blank structure.

connective tissue
Label the blank structure.

Simple Columnar ET
Identify the tissue.

lumen (cavity inside intestine)
Label the blank structure.

basement membrane
What is the layer separating connective tissue from epithelial tissue?

Psuedostratified Columnar ET
Identify the tissue.

lumen
what is white space?

goblet cell
Label the blank structure.

cilia
Label the blank structure.

basement membrane
Label the blank structure.

Stratified Squamous ET
Identify the tissue.

nuclei
Label the blank structure.

basement membrane
Label the blank structure.

connective tissue
Label the blank structure.

Stratified Cubiodal ET
Identify the tissue.

basement membrane
Label the blank structure.

duct lumen
Label the blank structure.

Stratified Columnar ET
Identify the tissue.

basement membrane
Label the blank structure.

connective tissue
Label the blank structure.

lumen
What is white space on top?

Transitional ET
Identify the tissue.

connective tissue
Label the blank structure.

basement membrane
Label the blank structure.

lumen
what is white space on top?

stratified columnar epithelium
Label the blank structure.

basement membrane
Label the blank structure.

underlying connective tissue
Label the blank structure.

transitional epithelium
Label the blank structure.

basement membrane
Label the blank structure.

connective tissue
Label the blank structure.

Loose Areolar CT
Identify the tissue.

elastic fibers
Label the blank structure.

ground substance
Label the blank structure.

fibroblast nuclei
Label the blank structure.

collagen fibers
Label the blank structure.

Loose Adipose CT
Identify the tissue.

adipocyte
Label the blank structure.

fat droplet
Label the blank structure.

Loose Reticular CT
Identify the tissue.

reticular fibers
Label the blank structure.

Dense Irregular CT
Identify the tissue.

fibroblasts
Label the blank structure.

collagen fibers
Label the blank structure.

Dense Regular CT
Identify the tissue.

collagen fibers
Label the blank structure.

fibroblasts
Label the blank structure.

Dense Elastic CT
Identify the tissue.

elastic fibers
Label the structure.

Hyaline Cartilage CT
Identify the tissue.

chondrocyte
Label the inner structure.

lacuna
Label the outter structure.

Elastic Cartilage CT
Identify the tissue.

elastic fibers
Label the blank structure.

chondrocyte
Label the inner structure.

lacuna
Label the outter structure.

Fibrocartilage CT
Identify the tissue.

collagen fibers
Label the blank structure.

chondrocytes in lacunae
Label the blank structure.

Bone CT
Identify the tissue.

osteocyte in lacunae
Label the blank structure.

Blood CT
Identify the tissue.
rbc (erythrocytes)
Label the blank structure.
wbc (lymphocyte)
Label the blank structure.
Thrombocytes (Platelets)
Label the small purple structure
Skeletal muscle
Identify the tissue.

nuclei
Label the blank structure.

striations
Label the blank structure.

Cardiac muscle
Identify the tissue.

intercalated disks
Label the blank structure.

nucleus
Label the blank structure.

Smooth muscle
Identify the tissue.

nuclei
Label the blank structure.

Nervous
Identify the tissue.

cell body of a neuron
Label the blank structure.

neuron process
Label the blank structure.

nuclei of neuroglia
Label the blank structure.
